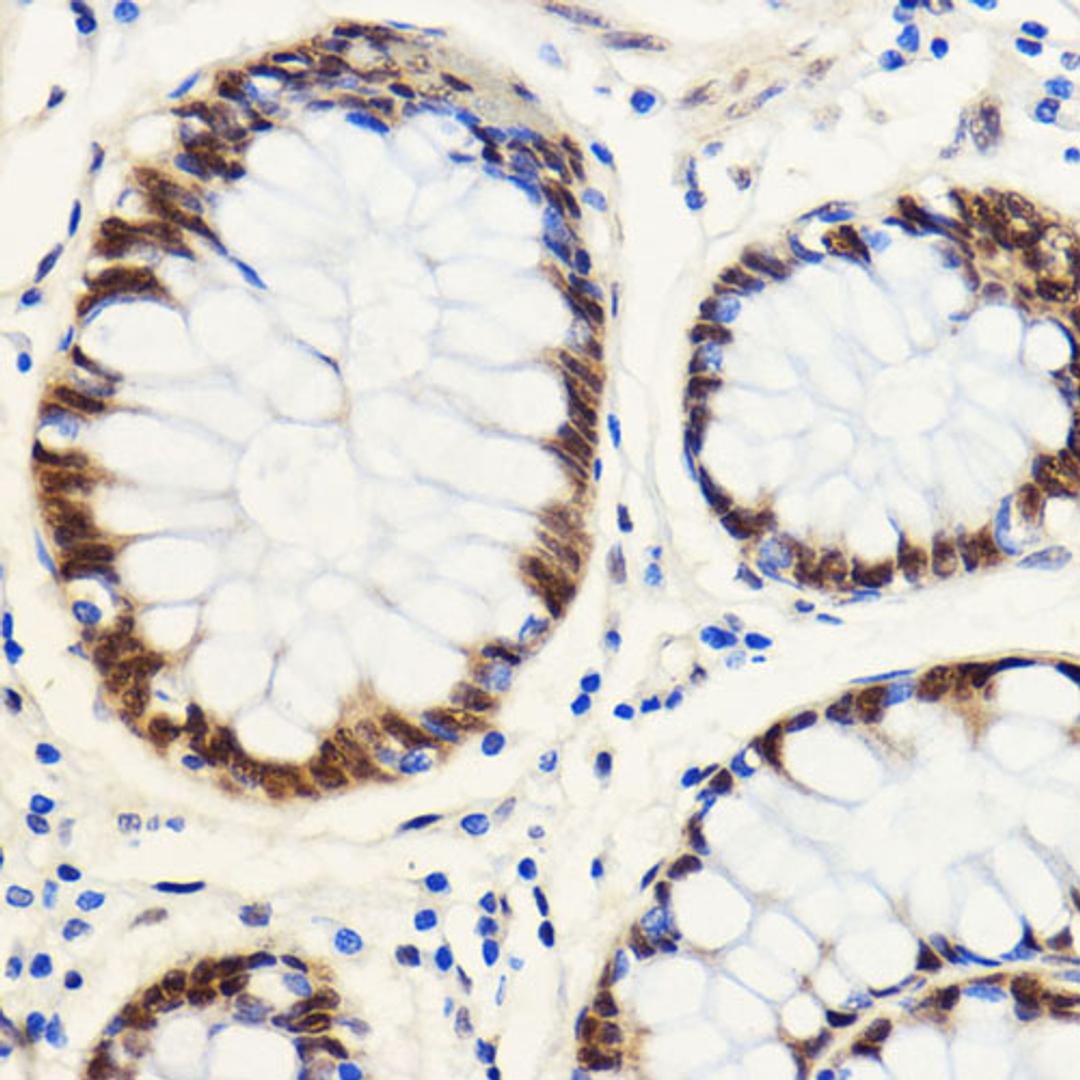
Immunohistochemistry - SNIP1 antibody (A16747)

Product & ReviewsAntibodies
SNIP1 Rabbit pAb
Product Details
- Cat. No.
- A16747
- Type
- Primary Antibody
- Clonality
- Polyclonal
- Host
- Rabbit

The supplier does not provide quotations for this antibody through SelectScience. You can search for similar antibodies in our Antibody Directory.
Description
This gene encodes a protein that contains a coiled-coil motif and C-terminal forkhead-associated (FHA) domain. The encoded protein functions as a transcriptional coactivator that increases c-Myc activity and inhibits transforming growth factor beta (TGF-beta) and nuclear factor kappa-B (NF-kB) signaling. The encoded protein also regulates the stability of cyclin D1 mRNA, and may play a role in cell proliferation and cancer progression. Mutations in this gene are a cause of psychomotor retardation, epilepsy, and craniofacial dysmorphism (PMRED).
Biological Information
- Clonality: Polyclonal
- Host: Rabbit
- Reactivity: Human, Rat